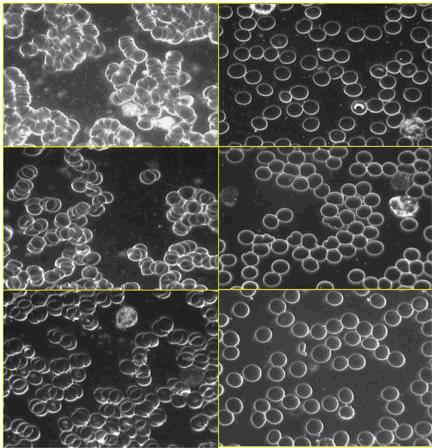

Γείωση: Ένα από τα σημαντικότερα θεραπευτικά μυστικά της φύσης
Μάρτιν Ζούκερ
Οι άνθρωποι στο παρελθόν είχαν μια ιδιαίτερη αγάπη για το χώμα και τη Γη και καθήμενοι στο έδαφος αισθάνονταν πως έρχονται σε επαφή με μια ζωοδότρια δύναμη. Ήταν καλό για το δέρμα τους να αγγίζει τη ιερή Γη και γι’ αυτό έβγαζαν τα παπούτσια τους για να περπατήσουν με τα γυμνά τους πόδια πάνω της. Η επαφή με Γη ήταν για αυτούς καταπραϋντική, ενδυναμωτική και θεραπευτική.
Καθ’ όλη την εξέλιξη τους οι άνθρωποι περπατούσαν ξυπόλυτοι και κοιμόντουσαν στο έδαφος, λαμβάνοντας από τη Γη μια φυσική και ήπια ηλεκτρική ενέργεια. Είναι σίγουρο ότι κι εσείς οι ίδιοι την έχετε αισθανθεί κάποια στιγμή στη ζωή σας. Ίσως στις διακοπές σας καθώς περπατούσατε με γυμνά πόδια στην αμμουδιά, αισθανθήκατε ένα γλυκό μούδιασμα ή μια ζεστασιά στα πόδια σας. Μια αίσθηση ευεξίας. Αυτή ακριβώς η αίσθηση είναι η ενέργεια του εδάφους που διεπερνά το σώμα, είναι το αποτέλεσμα της επαφής του σώματός σας που ως καλός αγωγός, έρχεται σε επαφή με τη Γη, δημιουργώντας ένα είδος ηλεκτρικού κυκλώματος.
Ο σύγχρονος τρόπος ζωής διαρκώς απομακρύνει τους ανθρώπους από αυτή τη ροή ενέργειας στο σώμα τους. Φοράμε παπούτσια με λαστιχένιους ή πλαστικούς πάτους που μπλοκάρουν την αγωγιμότητα και βέβαια δεν κοιμόμαστε πια στο έδαφος όπως στο παρελθόν.
Οι έρευνες αποκαλύπτουν τώρα πως αυτή η ενέργεια δημιουργεί μια ξεχωριστή και ευχάριστη αλλαγή στην φυσιολογία. Προάγει την υγεία, την ζωτικότητα, προσφέρει καλύτερο ύπνο, εναρμονίζει και σταθεροποιεί τους βασικούς βιολογικούς ρυθμούς του σώματος, περιορίζει (και συχνά εξαφανίζει) χρόνιες φλεγμονές και ανακουφίζει από πόνους. Η αποσύνδεση από αυτή τη φυσική πηγή ενέργειας που βρίσκεται κάτω απ’ τα πόδια μας, ενδέχεται να είναι ένας πολύ βασικός παράγοντας πίσω από την εκρηκτική αύξηση των κρουσμάτων των χρόνιων ασθενειών τις τελευταίες δεκαετίες και ειδικότερα των φλεγμοδών νοσημάτων. (Νόσος του Crohn, ελκώδης κολίτιδα, ψωρίαση, πολλαπλή σκλήρυνση κλπ)
Αυτές οι αποκαλύψεις είναι το κεντρικό θέμα του νέου βιβλίου Earthing (Γείωση) που είχα την τύχη να γράψω. Οι συνεργάτες συγγραφείς είναι ο γνωστός καρδιολόγος Stephen Sinatra, MD και ο Clint Ober, ένας εκπληκτικός ερευνητής που ανακάλυψε τα πλεονεκτήματα για την υγεία μας, από την επανασύνδεσή μας με τη Γη.
Οι παραπάνω φωτογραφίες αίματος σε dark field μικροσκόπιο είναι από τρεις ασθενείς στο ιατρείο του Dr Sinatra πριν (αριστερά) και μετά από γείωση 40 λεπτών (δεξιά). Οι φωτογραφίες δείχνουν καθαρά την αραίωση και αποσύνδεση των κυττάρων του αίματος.
Ο Dr Sinatra την περιγράφει ως την πλέον συναρπαστική ανακάλυψη στο χώρο της υγείας που αντιμετώπισε στα τριάντα χρόνια της καριέρας του. Τη θεωρεί ως μια απλή, πρακτική, αποτελεσματική και σαφώς οικονομικότερη μέθοδο ανιτμετώπισης κοινών ασθενειών που θα κάνει τους ανθρώπους υγειέστερους. Ειδικότερα στον τομέα του, πιστεύει πως θα βελτιώσει σημαντικά προβλήματα καρδιακής αρρυθμίας, αρτηριακής πίεσης, θρομβώσεων και κυκλοφορικών προβλημάτων και θα αυξήσει την ενέργεια των κυττάρων του αίματος. Πηγή έμπνευσής του ήταν ένα απλό πείραμα που έκανε χρησιμοποιώντας dark field μικροσκόπιο, που έδειξε θεαματική αλλαγή στη συμπεριφορά των κυττάρων του αίματος μετά από μόλις 40 λεπτά γείωσης. Οι αλλαγές φαίνονται καθαρά (εικ. 1)
Παρακάτω παρατίθενται μερικά βασικά σημεία του βιβλίου:
• Ο όρος «γείωση» αναφέρεται στην ανακάλυψη των σημαντικών πλεονεκτημάτων για την υγεία που προέρχονται από την επαφή-σύνδεση με την φυσική ηλεκτρική ενέργεια της επιφάνειας της Γης. Η επαφή αυτή επιτυγχάνεται είτε περπατώντας απλώς με γυμνά πόδια στο έδαφος είτε ερχόμενοι σε επαφή με ειδικές συσκευές-αγωγούς που μας μεταφέρουν την ενέργεια από το έδαφος ενώ εμείς καθόμαστε, δουλεύουμε ή κοιμόμαστε.
• Αυτές οι συσκευές «εσωτερικού χώρου» είναι συνδεδεμένες μέσω καλωδίου με μια σωστά γειωμένη πρίζα στο σπίτι, στο γραφείο κλπ ή με μια κατάλληλα γειωμένη μεταλλική ράβδο έξω. Οι συσκευές που διατίθονται για τη γείωση είναι ειδικά βαμβακερά σεντόνια και μαξιλάρια που επιτρέπουν να κοιμάσαι «γειωμένος» στο κρεβάτι σου, μαξιλάρια για την καρέκλα του γραφείου ή το πάτωμα που επιτρέπουν να δουλέυεις ή να χαλαρώνεις «γειωμένος» καθώς και ταινίες Velcro, συνδεδεμένες με γείωση, που τοποθετούνται στο σώμα σε συγκεκριμένα σημεία πόνου και φλεγμονών. Οι ταινίες αυτές έχουν χρησιμοποιηθεί επανειλημμένα στις έρευνες για τη Γείωση και έχουν εξαιρετικά κλινικά αποτελέσματα.
• Εκατοντάδες άνθρωποι – ενήλικες και παιδιά- έχουν επωφεληθεί από αυτές τις συσκευές για περισσότερο από μια δεκαετία. Οι εμπειρίες τους, όπως καταγράφονται στο βιβλίο, είναι εντυπωσιακές. Ποδηλατικές ομάδες στο Tour De France χρησιμοποίησαν υπνόσακους με γείωση και είδαν, εντυπωσιακά γρηγορότερη από το συνηθισμένο, ανάρρωση από τραυματισμούς και σωματική εξάντληση.
• Όλοι ζούμε και λειτουργούμε σε έναν ηλεκτρικό πλανήτη και ο καθένας μας είναι ένα σύνολο δυναμικών ηλεκτρικών κυκλωμάτων. Μέσα στο πολύπλοκο σώμα μας, τρισεκατομμύρια κύτταρα λαμβάνουν και μεταδίδουν ενέργεια στα πλαίσια των καθορισμένων βιοχημικών λειτουργιών τους. Η τροφοδοσία των θρεπτικών στοιχείων και του νερού στα κύτταρα ρυθμίζεται από ηλεκτρικά πεδία και κάθε τύπος κυττάρου έχει ένα φάσμα συχνοτήτων στο οποίο λειτουργεί. Η καρδιά, ο εγκέφαλος, το νευρικό σύστημα, οι μύες και το ανοσοποιητικό μας σύστημα είναι έξοχα παραδείγματα ηλεκτρικών υποσυστημάτων που λειτουργούν μέσα στο βιοηλεκτρικό σώμα μας. Η αλήθεια είναι πως όλες μας οι κινήσεις, συμπεριφορές και πράξεις ενεργοποιούνται με ηλεκτρισμό. Η έρευνα για την Γείωση δείχνει πως η σύνδεση με τη Γη ενεργοποιεί την άμεση αλλαγή των λειτουργιών του σώματος με βελτίωση της κυκλοφορίας του αίματος, του νευρικού και ανοσοποπιητικού συστήματος καθώς και της λειτουγίας των μυών.
• Όλα τα ηλεκτρικά συστήματα και συσκευές είναι γειωμένες, δηλαδή είναι ισοσταθμισμένες από την ηλεκτρική ενέργεια της Γης. Χωρίς γείωση, οι συσκευές δεν θα λειτουργούσαν σωστά. Παρομοίως, όταν είναι σε επαφή με τη Γη, το σώμα λαμβάνει ένα ηλεκτρικό σήμα που ομαλοποιεί και ισοσταθμίζει τα πολλαπλά βιολογικά του συστήματα και μηχανισμούς. Το σήμα αυτό επίσης φαίνεται να είναι πηγή αρνητικά φορτισμένων ελεύθερων ηλεκτρονίων που υπάρχουν σε απεριόριστη ποσότητας στην επιφάνεια της Γης. Το στοιχείο που μελέτησαν οι επιστήμονες στην έρευνα για τη γείωση, είναι πως η μεταφορά αρνητικά φορτισμένων ηλεκτρονίων στο σώμα φαίνεται να εξουδετερώνει τα θετικά φορτισμένα ηλεκτρόνια των ελεύθερων ριζών τα οποία μετά από χρόνια φλεγμονώδη δραστηριότητα οδηγούν σε πολλές κοινές ασθένειες. Θεωρούμε πως το καλύτερο αντιφλεγμονώδες πάνω στον πλανήτη, είναι ο ίδιος ο πλανήτης! Περαιτέρω πιστεύουμε πως μια καταστρεπτική χρόνια φλεγμονή μπορεί να είναι το αποτέλεσμα της ανεπάρκειας αρνητικών ηλεκτρονίων, η οποία αποκαθίσταται με την επαφή μας με την αστείρευτη δεξαμενή ελεύθερων ηλεκτρονίων της Γη.
• Όπως το φως του ήλιου μας προσφέρει την βιταμίνη D, η Γη μας προσφέρει ένα άλλο σημαντικό στοιχείο που ονομάζεται βιταμίνη G (Ground=έδαφος). Τον θεωρούμε ως έναν αγνοημένο παράγοντα πρόκλησης της νόσου, ένα στοιχείο που λείπει. Ο Gary Schwartz, PhD, καθηγητής ψυχολογίας και ιατρικής στο Πανεπιστήμιο της Αριζόνα, δείχνει ότι η Γείωση μπορεί να είναι τόσο θεμελιώδους σημασίας όσο το φως του ήλιου, ο αέρας, το νερά και τα θρεπτικά συστατικά.
Η συναρπαστική ανακάλυψη της Γείωσης
Σε όλη την ιστορία, διάφοροι πολιτισμοί ανά τον κόσμο τίμησαν τη σύνδεση με την Γη και περιέγραψαν την ενέργειά της με διάφορους τρόπους. Σε καποιους από εσάς μπορεί να είναι γνωστή ως Qi στην παραδοσιακή κινέζικη ιατρική και Prana στην Αγιουρβέδα.
Μέχρι τώρα, τα σημαντικά οφέλη αυτής της ενέργειας για την υγεία έχουν παραμείνει σε μεγάλο βαθμό άγνωστα. Χάρη στην περιέργεια και την επιμονή του Clinton Ober, ενός πρωτοπόρου του κλάδου της καλωδιακής τηλεόρασης, τα οφέλη αυτά έρχονται στην επιφάνεια. Ο Ober ήταν επικεφαλής της μεγαλύτερης εταιρείας εγκαταστάσεων συστημάτων καλωδιακής τηλεόρασης στην Αμερική. Το 1993, σε ηλικία 49 ετών και στο απόγειο της καριέρας του, αρρώστησε βαριά όταν ένα απόστημα σχεδόν κατέστρεψε το συκώτι του. Όταν ανέκτησε την υγεία του αποφάσισε να πουλήσει όλα τα υπάρχοντά του και να ψάξει για έναν ανώτερο σκοπό στη ζωή του. Ταξίδεψε σε όλες τις ΗΠΑ για τέσσερα χρόνια ψάχνοντας όπως έλεγε ο ίδιος «για την αποστολή του». Μια μέρα στη Σεντόνα της Αριζόνα, καθισμένος σε ένα παγκάκι στο πάρκο, βλέποντας τους περαστικούς να πηγαινοέρχονται, παρατήρησε πως όλοι φορούσαν παπούτσια με συνθετική σόλα. Αναρωτήθηκε αν τα συγκεκριμένα παπούτσια που αντκατέστησαν τα δερμάτινα από το 1960 και μετά, μπορεί να είχαν κάποια επίδραση στην υγεία. Συνειδητοποίησε πως ο ίδιος αλλά και οι περισσότεροι περαστικοί ήταν «μονωμένοι» από την ηλεκτρική ενέργεια της Γης. Η σκέψη του πήγε πίσω, στα χρόνια που δούλευε στην καλωδιακή τηλεοραση. Πριν την καλωδιακή τηλεόραση, η εικόνα της τηλεόρασης συχνά χάλαγε λόγω κηλίδων, «χιονών» ή από παράσιτα που προκαλούνταν από ηλεκτρομαγνητικές παρεμβολές. Στην καλωδιακή εποχή, τα συστήματα σε κάθε σπίτι ήταν γειωμένα και θωρακισμένα και η μετάδοση του σήματος γίνεται μέσω καλωδίου ώστε να αποτρέπονται παρεμβολές εξωτερικών σημάτων. Το καλώδιο αποτελείται από ένα εσωτερικό αγωγό χαλκού, ένα στρώμα μόνωσης και το εξωτερικό κάλυμμα. Αυτό το κάλυμμα είναι συνδεδεμένο στη Γη,σε μια ράβδο γείωσης. Αυτή είναι η βασική αρχή της γείωσης, της σύνδεσης δηλαδή των ηλεκτρικών συστημάτων των σπιτιών και κάθε κτιρίου με το ενεργειακό πεδίο της Γης, με σκοπό την σταθερότητα και την προστασία από τα ελεύθερα ηλεκτρικά φορτία.
Ο Ober αναρωτήθηκε αν θα μπορούσε άραγε αυτή η ενέργεια να προστατεύσει τον ανθρώπινο οργανισμό από τα ηλεκτρομαγνητικά πεδία (EMF) του περιβάλλοντος που πολλοί θεωρούν ύπουλα και επικίνδυνα για την υγεία; Θα μπορούσε να παράσχει σταθερότητα στο σώμα; Ήξερε ότι το ανθρώπινο σώμα είναι καλός αγωγός του ρεύματος. Αποφάσισε λοιπόν να κάνει ένα απλό πείραμα στον εαυτό του. Τοποθέτησε ένα μεταλλικό πλέγμα πάνω στο κρεβάτι του. Συνέδεσε πάνω στο πλέγμα ένα καλώδιο με κλιπ και έριξε το καλώδιο έξω από το παράθυρο όπου το συνέδεσε σε μια ράβδο γειωμένη στο έδαφος. Στη συνέχεια ξάπλωσε πάνω στο πλέγμα μετρώντας την τάση στο σώμα του. Τότε βρήκε πως όσο ήταν «γειωμένος» πάνω στο πλέγμα, τα ηλεκτρομαγνητικά κύματα είχαν εξαφανιστεί και η τάση του σώματός του ήταν κοντά στο μηδέν. Χωρίς να το καταλάβει αποκοιμήθηκε και ξύπνησε το επόμενο πρωΐ. Είχε κοιμηθεί για πρώτη φορά χωρίς παυσίπονα μετά από πολλά χρόνια που ταλαιπωρείτο από ανυπόφορους πόνους και αϋπνίες.
Επανέλαβε το πείραμα κάθε νύχτα για μια εβδομάδα. Τα αποτελέσματα ήταν τα ίδια και επιπλέον οι πόνοι του μειώθηκαν σημαντικά. Αποφάσισε να μιλήσει στους φίλους του για το πείραμά του και τότε αυτοί του ζήτησαν να τους φτιάξει ένα μεταλλικό πλέγμα για τα κρεβάτια τους. πράγμα που φυσικά δέχτηκε. Τα αποτέλέσματα ήταν ίδια και για αυτούς. Καλύτερος ύπνος και λιγότεροι πόνοι.
Επικοινώνησε με ερευνητές πανεπιστημίων προκειμένου να πάρει μια εξήγηση αλλά κανείς δεν γνώριζε κάτι για αυτό και κανείς δεν ενδιαφέρθηκε να το μελετήσει. Αποφασισμένος να βρει μόνος του απαντήσεις και έχοντας πάρει πολύτιμες συμβουλές από προπτυχιακούς φοιτητές του πανεπιστημίου, ξεκίνησε την επιστημονική οδύσσειά του, αν και δεν ήταν επιστήμονας ο ίδιος. Δώδεκα χρόνια μετά, συνεχίζει ακόμα. Έχει οργανώσει και εμπνεύσει δεκάδες μελέτες ειδικών επιστημόνων οι οποίοι επιβεβαίωσαν τις διαπιστώσεις του για βελτίωση του ύπνου και μείωση των πόνων. Κατέδειξαν με σαφήνεια ότι η Γείωση έχει ισχυρή επιρροή στη λεπτή ισορροπία μεταξύ της υγείας και της ασθένειας, καθώς και στο προσδόκιμο ζωής. Στη διάρκεια όλης αυτής της περιόδου, ανάπτυσσε και βελτίωνε συνεχώς συστήματα Γείωσης για επιστημονικές μελέτες αλλά και για χρήση από ιδιώτες που ενδιαφέρθηκαν.
Ομαλοποίηση μέσω Γείωσης
Για μένα, η ιδέα της επανασύνδεσης με τη Γη, αποκάλυψε ένα από τα σημαντικότερα θεραπευτικά μυστικά της φύσης. Προσωπικά διαπίστωσα άμεση διακοπή του συνδρόμου των ανήσυχων ποδιών που αντιμετώπιζα όταν άρχισα να κοιμάμαι «γειωμένος» πριν από δύο χρόνια. Πλέον κοιμάμαι «γειωμένος» είτε βρίσκομαι σπίτι είτε σε ταξίδια. Με τον καιρό, το ενοχλητικό ξύπνημα τη νύχτα για ούρηση, συνηθισμένο φαινόμενο για ανθρώπους στην ηλικία μου (72) έχει σταδιακά ελατωθεί. Άλλες φορές ξυπνάω μόνο μια φορά και άλλες καθόλου. Ανάλογη βελτίωση έχει και η σύζυγός μου που ταλαιπωρείται από μυοσκελετικά προβλήματα.
Για να αντιληφθείτε μόνοι σας την εμπειρία της γείωσης, απλώς καθίστε ή περπατήστε ξυπόλυτοι στο γρασίδι, στο χώμα ή στην άμμο, δηλαδή σε επιφάνειες-καλούς αγωγούς. Ξύλο, άσφαλτος και πλαστικό δεν είναι καλοί αγωγοί. Σταθείτε για τουλάχιστον μισή ώρα και στο τέλος θα παρατηρήσετε ότι αισθάνεστε πιο ήρεμοι και αν είχατε κάποιο πόνο όταν ξεκινήσατε θα έχει μειωθεί και ίσως θα έχει εξαφανιστεί.
Ο βιοφυσικός James Oschman, PhD, κορυφαίος ειδικός και συγγραφέας για την ενεργειακή ιατρική, συνοψίζοντας αναφέρει:
«Τη στιγμή που τα πόδια σας πατάνε στη Γη ή συνδέεστε με αυτή μέσω καλωδίου, αλλάζει η ψυχολογία σας. Ξεκινά αμέσως η ομαλοποίηση του οργανισμού και η αντιφλεγμονώδης λειτουργία του σώματός σας. Οι άνθρωποι εμφανίζουν διαρκώς φλεγμονές επειδή είναι αποσυνδεδεμένοι από τη Γη, την πηγή των ηλεκτρονίων που μπορούν να εξουδετερώσουν τις ελεύθερες ρίζες που προκαλούν την καταστροφή των κυττάρων τους.»
Για περισσότερες πληροφορίες μπορείτε να διαβάσετε το βιβλίο (είναι μόνο στα αγγλικά) και να βρείτε λεπτομέρειες για τα αποτελέσματα των ερευνών που διεξάγονται αλλά και τις εντυπώσεις ανθρώπων που δοκίμασαν τη μέθοδο της γείωσης.
Τα οφέλη της Γείωσης
Για περισσότερο από δέκα χρόνια, οι έρευνες για τη Γείωση αλλά και οι πληροφορίες από ανθρώπους που δοκίμασαν τη μέθοδο της Γείωσης έχουν δείξει ένα πλήθος θετικών επιδράσεων. Μερικές από αυτές είναι:
• Μείωση έως και εξάλειψη των συμπτωμάτων πολλών φλεγμονοδών νοσημάτων
• Μείωση έως και εξάλειψη χρόνιων πόνων
• Καλύτερος ύπνος και εξάλειψη αϋπνίας
• Αυξημένη ενέργεια
• Λιγότερο στρες και περισσότερη ηρεμία
• Ομαλοποίηση των βιολογικών ρυθμών του σώματος
• Πιο αραιό αίμα, βελτίωση της αρτηριακής πίεσης και της κυκλοφορίας
• Ένταση των μυών και ανακούφιση από πονοκεφάλους
• Προστασία από ηλεκτρομαγνητικά πεδία
• Ταχύτερη ανάρρωση και ανάκαμψη μετά από τραυματισμούς και έντονη
αθλητική δραστηριότητα
Συνεχίζοντας, ο Δρ Μέρκολα, καταξιωμένος, κορυφαίος Αμερικανός ιατρός με πολλές διακρίσεις στον αγώνα του για την ολιστική ιατρική, όχι μόνο μιλά για τα οφέλη της γείωσης, αλλά σε άρθρο για τους κινδύνους που ελλοχεύουν φάρμακα κατά των καρδιαγγειακών νοσημάτων, προτείνει και την πλήρη κατάργηση φαρμάκων όπως το διάσημο Plavix και την αντικατάστασή τους με την απλή γείωση για τους λόγους που διαβάσατε παραπάνω.
Θεωρεί ότι η φυσική, χωρίς μηχανήματα, γείωση είναι εξίσου αποτελεσματική, αν όχι καλύτερη.
Ο Δρ James Oschman, βιολόγος, βιοφυσικός ειδικός στο πεδίο της ενεργειακής φαρμακευτικής, συγγραφέας πολλών βιβλίων, μιλάει για την τεράστια αντιοξειδωτική δράση που επιφέρει η γείωση στον οργανισμό, καθώς και τα εξαιρετικά οφέλη του στο σύνολο της υγείας μας.
«Όταν γειώνεστε, μεταφέρονται ελεύθερα ηλεκτρόνια από τη γη στο σώμα σας. Και αυτά τα ελεύθερα ηλεκτρόνια είναι ίσως τα καλύτερα αντιοξειδωτικά που υπάρχουν».
Επίσης, για να δείξει την επιστημονική βάση που έχει το θέμα της γείωσης, εξηγεί τι συμβαίνει όταν ένα άτομο τραυματίζεται:
«Ακόμα και με το παραμικρό χτύπημα, π.χ. ένα χτύπημα στην πόρτα, ο οργανισμός αποστέλλει λευκά αιμοσφαίρια (ουδετερόφιλα) στο σημείου του τραύματος.
Τα ουδετερόφιλα εκκρίνουν δραστικές μορφές οξυγόνου (ROS), που ονομάζονται ελεύθερες ρίζες. Αυτό αναφέρεται και ως οξειδωτικό ξέσπασμα. Αυτά είναι σαν το Pac – Man. Είναι πολύ σημαντικά μόρια τα οποία διαλύουν τα πάντα στο πέρασμά τους. Εάν τα βακτήρια έχουν εισέλθει διαμέσου του δέρματος σας, αυτές οι ελεύθερες ρίζες θα τα εντοπίσουν και θα τα καταστρέψουν. Εάν υπάρχουν κατεστραμμένα κύτταρα, τότε θα τα διαλύσουν επίσης, ώστε να αφήσουν χώρο για την δημιουργία καινούριων κυττάρων με σκοπό την αποκατάσταση των ιστών.
Αυτή η διαδικασία είναι γνωστή ως φλεγμονώδη απόκριση.
Το πολύ σημαντικό που έχουμε ανακαλύψει, είναι το εξής: τώρα καταλαβαίνουμε γιατί υπόκεισθε στη φλεγμονώδη απόκριση, η οποία έχει πέντε χαρακτηριστικά: πόνος, ερυθρότητα, θερμότητα, απώλεια ελαστικότητας και πρήξιμο.Όλα αυτά είναι αποτελέσματα της φλεγμονής, τα οποία όμως όπως αποδεικνύεται δεν είναι απαραίτητο να συμβούν.
Η φλεγμονή, η οποία στην ιατρική, θεωρείται ένα σημαντικό μέρος της επούλωσης, είναι πράγματι ένα τεχνούργημα που προκαλείται από την έλλειψη ηλεκτρονίων στους ιστούς σας. Αυτό που συμβαίνει είναι ότι τα ουδετερόφιλα παραδίδουν αυτές τις δραστικές μορφές οξυγόνου στο σημείο του τραύματος, αλλά μέρος από αυτές τις ελεύθερες ρίζες μπορεί να διαρρεύσουν στον περιβάλλοντα ιστό και να τον βλάψουν. Αυτό είναι που δημιουργεί τη φλεγμονώδη απόκριση.»
Λέει λοιπόν, ότι στις έρευνες που έχουν διεξαχθεί γα την γείωση, έχει παρατηρηθεί, ότι εάν μετά από ένα τραύμα ακολουθήσει γείωση, τότε τα ελεύθερα ηλεκτρόνια εισχωρούν στους ιστούς και εξουδετερώνουν τις ελεύθερες ρίζες, αφού τα ηλεκτρόνια είναι αρνητικά φορτισμένα, ενώ οι ελεύθερες ρίζες είναι θετικά φορτισμένες, με αποτέλεσμα να αλληλοεξουδετερώνονται.
«Αυτό που συμβαίνει με τη γείωση είναι αυτό που ονομάζω «προστασία από παράπλευρες ζημιές». Ζημιές που δεν θα έπρεπε να λαμβάνουν χώρα αλλά συμβαίνουν γιατί έχουμε αποσυνδέσει τον εαυτό μας από τη Γη διαμέσου του λάστιχου και του πλαστικού στις σόλες των παπουτσιών μας.»
Δεν γνωρίζω για την λειτουργικότητα των λεγόμενων «συσκευών γείωσης» αλλά η άποψή μου είναι ότι είναι παράλογο, για ένα τόσο φυσικό πράγμα, όπως το ξυπόλυτο περπάτημα στην Γη, να προσπαθήσουμε να το αντικαταστήσουμε με «συσκευές γείωσης». Επιτέλους, δεν είμαστε μηχανήματα που μας λείπει ένα καλώδιο για να λειτουργούμε «ορθά». Κατά τη γνώμη μου, το πρόβλημα είναι ότι χάνουμε την επαφή μας με την μητέρα Γη.
Ζούμε σε κλειστά διαμερίσματα «σπιρτόκουτα», φοράμε πλαστικά, οι δρόμοι είναι όλοι ασφαλτοστρωμένοι, η τροφή μας σε λίγο θα προέρχεται από εργαστήρια και απορούμε γιατί νοσούμε νοητικά και σωματικά!
Το ότι το προσδόκιμο ζωής έχει αυξηθεί, δεν θα έπρεπε να μας λέει τίποτα. Υπάρχουν χιλιάδες ηλικιωμένοι οι οποίοι ζουν σε κατάσταση φυτού για 10 και 20 χρόνια και αυτό το ονομάζουν αύξηση του προσδόκιμου ζωής για το οποίο θα έπρεπε να είμαστε πολύ περήφανοι!
Θεωρώ ότι είναι ντροπή για τον σύγχρονο άνθρωπο, να μελετάει τις ευεργετικές ιδιότητες του να περπατάει κανείς ξυπόλυτος στην Γη. Για την ακρίβεια είναι τρομακτικό το να συνειδητοποιούμε ότι τα αυτονόητα, γίνονται αντικείμενα «επιστημονικής έρευνας» για να μας πουν με επιστημονικές ορολογίες ό,τι πιο απλό:
Ότι εάν αποκοπείς από την πηγή σου, αργά η γρήγορα θα πεθάνεις, όπως αν κόψεις ένα κλαδί από το κορμό του δέντρου.
Μάρτιν Ζούκερ
Πηγή: http://www.awakengr.com/giosi-ena-apo-ta-simantikotera-therapeftika-mystika-tis-fysis/




